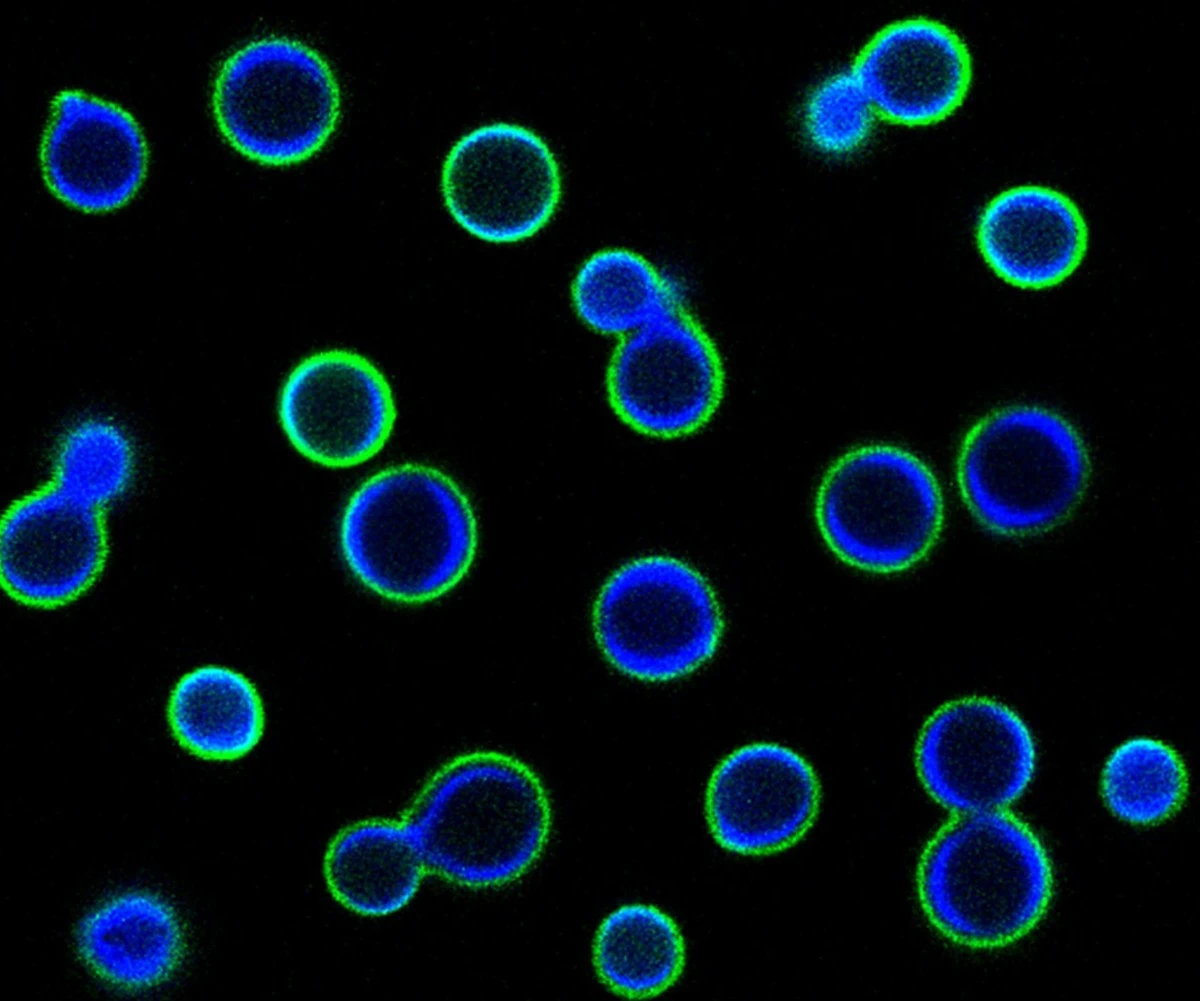
dlaczegoswiatmo-extra-1.webp Dlaczego świat może stracić wyjątkowe gatunki grzybów, o których istnieniu nawet nie wiemy - image 1

Spacerując po polskich lasach, rzadko zastanawiamy się, co tak naprawdę kryje się pod ściółką. Najnowsze badania prowadzone przez naukowców, w tym zespół z Uniwersytetu w Coimbrze, wskazują na alarmujący problem: wiele unikalnych gatunków grzybów znika z powierzchni Ziemi na zawsze.
To nie jest tylko kolejna informacja o utracie bioróżnorodności. Mówimy o całych gałęziach ewolucji, które wyginą, zanim zdążymy je w ogóle poznać. Dlaczego ignorujemy świat, który odpowiada za obieg składników odżywczych w naszych lasach?
Dlaczego niektóre grzyby są warte więcej niż rzadkie dinozaury?
Większość z nas kojarzy grzyby z jesiennym zbieraniem podgrzybków czy borowików. Jednak światowa mikologia to coś znacznie głębszego. Badacze przeanalizowali 94 gatunki grzybów należące do tzw. rodzajów monotypowych. To organizmy, które posiadają unikalną historię genetyczną, budowaną przez miliony lat.
Oto co odkryli naukowcy:
- 9 gatunków jest już bezpośrednio zagrożonych wyginięciem.
- Dla aż 56 gatunków brakuje jakichkolwiek danych – nie wiemy o nich niemal nic.
- Tylko 28 gatunków oceniono jako bezpieczne.
Najbardziej szokujący jest fakt, że wiele z tych organizmów opisano dekadę temu i od tamtej pory nikt ich nie widział. Możemy tracić gatunki, których nawet nie zdążyliśmy w pełni skatalogować w naszych atlasach przyrodniczych.
Problem „niewidzialnego” dziedzictwa
Dlaczego tak mało wiemy o tak istotnych organizmach? Jak zauważa Susana Cunha, koordynatorka badań, grzyby przez lata były pomijane w globalnych strategiach ochrony przyrody. Podczas gdy ratujemy pandy czy rysie, grzyby, które rozkładają materię organiczną i użyźniają glebę w polskich ogrodach, pozostają w cieniu.
Brak inwestycji w badania mykologiczne to główna przyczyna tego stanu. Bez funduszy na badania terenowe i analizy DNA środowiskowego, nasze zrozumienie ekosystemu pozostaje na poziomie sprzed wielu lat.
Jak możemy pomóc?
Choć wydaje się, że problem jest odległy, każdy z nas może wpłynąć na stan wiedzy o grzybach. Istnieją nowoczesne techniki, takie jak analiza DNA z gleby, które pozwalają identyfikować gatunki bez ich fizycznego kolekcjonowania. Warto wspierać inicjatywy naukowe i obywatelskie, które zajmują się dokumentowaniem lokalnej bioróżnorodności.
Możesz zacząć od zwrócenia większej uwagi na to, co rośnie w Twoim ogrodzie lub najbliższym parku. Czasami nawet niepozorny, dziwny grzyb na kawałku gnijącego drewna może być obiektem poszukiwań naukowców.
Czy kiedykolwiek zastanawiałeś się, jak wiele gatunków grzybów przestało istnieć w Twojej okolicy w ciągu ostatnich lat? Podziel się w komentarzu, czy zauważasz mniej różnorodności w naszych lasach.









